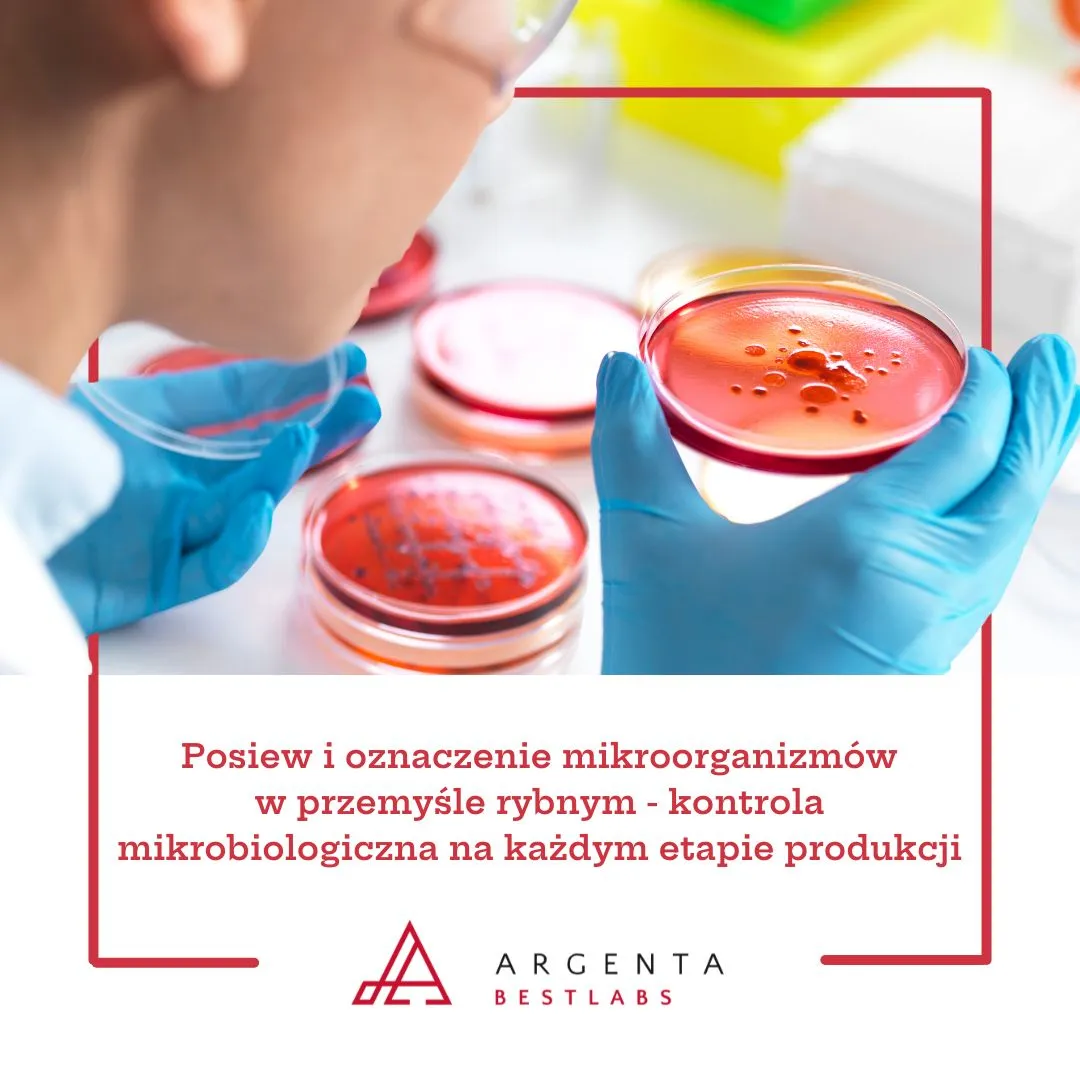
Posiew i oznaczenie mikroorganizmów w przemyśle rybnym - kontrola mikrobiologiczna na każdym etapie produkcji

Posiew i oznaczenie mikroorganizmów w przemyśle rybnym - kontrola mikrobiologiczna na każdym etapie produkcji
Posiew i oznaczenie mikroorganizmów w przemyśle rybnym to kluczowy etap kontroli jakości, umożliwiający precyzyjną identyfikację patogenów i zapewnienie bezpieczeństwa produktów.
czytaj całość